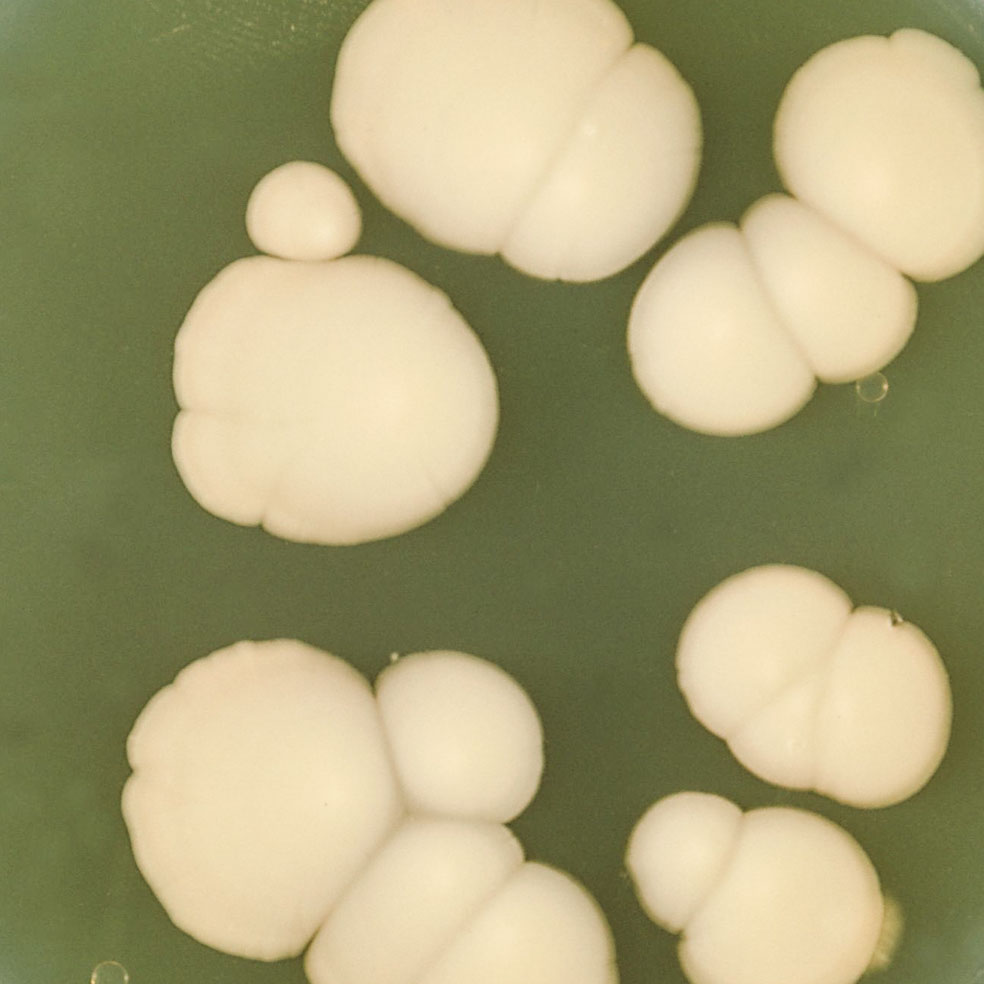
texto alternativo

Huéspedes del ser humano Con los microbios a cuestas La tiña y otros habitantes –poco amistosos– del planeta cuerpo

La tiña acecha estos días a los adolescentes que se rasuran la cabeza en las peluquerías. Provocada por un hongo que halla alimento en nuestro cabello, piel y uñas, es apenas uno de los millones de microorganismos para los cuales nuestro cuerpo significa comida, transporte e, incluso, seguir vivos.
Lunes, 23 de Enero 2023, 15:52h
Tiempo de lectura: 5 min
La barba, los pies, las ingles y el cuero cabelludo. Por ahí nos ataca la tiña, esa enfermedad altamente transmisible que se extiende últimamente por algunas peluquerías españolas. Solo en aquellas, matizan desde el sector, que no son lo suficientemente estrictas con la higiene de sus máquinas de rasurar.
Y esa es la cuestión. Los casos detectados –entre adolescentes, sobre todo, más de un centenar– guardan relación con la creciente moda de realizarse rasurados y degradados en el cuero cabelludo. La explicación es sencilla: si una persona con tiña se hace un corte de estos en una peluquería, contamina las cuchillas de las máquinas y, si no se higienizan adecuadamente, transmite los parásitos que la causan al cliente siguiente.
El origen se halla en tres tipos de hongos: Microsporum, Epidermophyton y Trichophyton, criaturas milenarias que invaden las capas superficiales de la piel, el pelo y las uñas. Es donde encuentran alimento y se reproducen. Por eso una vez ahí se multiplican, generando una erupción cutánea redondeada que se deshace en escamas y causa picor. Si no se trata a tiempo, puede provocar dolor, fiebre, caída del cabello e, incluso, alopecia en las zonas afectadas. Su capacidad de transmisión es muy elevada: basta tocar a una persona infectada u objetos contaminados como las máquinas en cuestión, peines, ropa, suelo de duchas, piscinas...
En nuestro cuerpo habita una cantidad de microorganismos 15.000 veces mayor que toda la población de la Tierra
La tiña es, en todo caso, apenas un ejemplo de los microbios que nos acechan. Nuestro cuerpo funciona, al fin y al cabo, como un ecosistema andante con una desmesurada –y muy inquietante– capacidad de atracción para parásitos, bacterias y demás aprovechados de un mundo mayormente microscópico. Por si tiene dudas, agárrese: en nuestro interior habita una cantidad de microorganismos 15.000 veces mayor que toda la población de la Tierra. Y, ojo, mejor no abra la boca de asombro porque dejará al descubierto los más de 500 tipos de bacterias que residen en ella.
Otras 500 especies, un kilo y medio de nuestro peso, viven en los intestinos o en el estómago, ayudando a producir vitaminas o digerir la comida. Mientras lee estas líneas, además, pequeños ácaros del género Demodex campan a sus anchas en los folículos de sus pestañas donde se alimentan de células epidérmicas. Algunas levaduras microscópicas, por su parte, aprovechan para asentarse en su lengua.
En todo caso, no se apure: la mayoría de los 90 billones de microorganismos que vive con usted son inofensivos o, incluso, beneficiosos, aunque la convivencia en ocasiones resulte complicada. Es lo que sucede cuando algunos hongos invaden recovecos húmedos de la piel provocando micosis; o cuando el virus del herpes zóster, latente en nuestras terminaciones nerviosas, se reactiva por el estrés; o cuando tomamos antibióticos que, mientras acaban con los patógenos, liquidan bacterias buenas como el Lactobacillus acidophilus, protector de los intestinos o la vagina. Repasemos el catálogo:
Otros diez huéspedes del cuerpo humano
El piojo del cabello, Pediculus humanus capitis, es un insecto parásito sin alas de entre uno y dos milímetros que se aferra al pelo con sus garras y segrega un pegamento junto a sus huevos (las liendres) para unirlos al pelo. Allí se alimenta de restos de piel, grasa y sangre, causando cierto cosquilleo, picor e irritación.
Ácaros del género Demodex, minúsculos artrópodos alargados con patas rechonchas, habitan en los folículos capilares de frente, cejas y pestañas, donde se alimentan de sebo. A veces abandonan estos confortables lugares para dar un paseo nocturno por la cara. Aumentan con la edad: casi todos los ancianos los tienen.
Si uno no se lava los dientes con frecuencia, en ellos se forma una biopelícula de cientos de bacterias entre las que predominan los estreptococos. Estos microorganismos se quedarán allí fermentando azúcares y produciendo polímeros pegajosos que forman la base de la placa dental y propician la aparición de caries.
Cuando uno sufre la varicela, el virus varicela-zóster se queda para siempre en el organismo, latente en los nervios de la columna vertebral. El estrés, el envejecimiento o las alteraciones del sistema inmune pueden reactivarlo, causando dolor agudo y manchas y ampollas en la piel: el famoso herpes zóster.
Unas 500 especies de bacterias viven dentro de los intestinos para metabolizar hidratos de carbono, producir nutrientes y vitaminas o prevenir infecciones. Una de las mejor estudiadas es la Escherichia coli, normalmente inofensiva, pero que tiene algunas cepas que pueden provocar diarreas e incluso úlceras intestinales.
En la vagina viven bacterias que segregan ácido láctico para mantener a raya a otros microorganismos hostiles presentes en la flora vaginal, como la Candida albicans. Cuando se produce un desequilibrio, por alteraciones hormonales o el uso de algunos jabones, esta levadura entra en acción y causa vaginitis.
Trichophyton y Epidermophyton son dos géneros de hongos que se pegan a los pies en las duchas públicas, ocasionando una infección conocida como tiña podal o pie de atleta. Estos microorganismos proliferan en zonas cálidas y húmedas, por lo que se recomienda tener los pies limpios y secos, sobre todo entre los dedos.
Más de cien tipos del virus del papiloma humano (HPV) se pueden contraer con las relaciones sexuales o el contacto con una piel afectada. Suelen provocar verrugas, manchas blancas y hasta cánceres genitales, y hay personas que no presentan síntomas, pero sí contagian esta infección, que es crónica e incurable.
Una duodécima parte de nuestro genoma se basa en secuencias de ADN de virus que infectaron a nuestros ancestros hace millones de años. Ese genoma fósil y parásito ha evolucionado con nosotros y pueden insertar copias de ellos en nuestro ADN, lo que puede causar, según algunos expertos, nuevas enfermedades.
La piel puede albergar cerca de un billón de microorganismos. Algunos tienen una presencia temporal en células cercanas a glándulas sebáceas, e incapaces de reproducirse, mueren al cabo de unas horas. Otras bacterias residentes, como la Staphylococcus epidermidis, metabolizan sudor, sebo y producen el olor.

-
1 Pódcast | Sexo y pasión en la corte: la vida íntima de los reyes de España
-
2 ¿Quién mató a Matthew Perry? Así fueron sus últimos días
-
3 Lujo, videojuegos y un intento de asesinato, el oscuro exilio del exdictador sirio en Moscú
-
4 ¿Me debo preocupar si me levanto por la noche a hacer pis?
-
5 El cartón es el nuevo termómetro de la economía